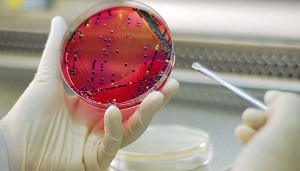
«Красная» биотехнология ЕАЭС – перспективы и наработки

Биотехнология – термин, с которым связывают как множество рациональных вещей: научных и технологических наработок, перспективных исследований, планов и государственных программ, так и иррациональных порой страхов, домыслов и истолкований.
С биотехнологиями сегодня сталкивается практически каждый житель нашей планеты. Причём зародились они в глубокой древности – ещё в ту пору, как люди обратили внимание на то, что молоко можно путём сквашивания превратить в молочнокислые продукты, фруктовые и ягодные соки – в вино, а дрожжевой белок придаёт изделиям из теста полезные качества и улучшает их вкус. Обратили внимание и начали использовать эти явления осознанно, экспериментируя с ними и добиваясь весьма значительных результатов в этих экспериментах.
Сегодня биотехнологии применяются в различных сферах человеческой деятельности – от медицины и пищевой промышленности до сельского хозяйства. Условно они разделены на несколько направлений, каждому из которых профессионалы присвоили определённый цвет. Так красный означает, что сфера применения биотехнологии связана со здравоохранением. Это прежде всего лекарства, но не только. Белый цвет – это биотехнологии, используемые в промышленности, в том числе при создании экоматериалов. Зелёные биотехнологии – все, что связано с сельским хозяйством, а также сюда часто относят биоэнергетику. Есть ещё жёлтая биотехнология, которая используется при производстве продуктов питания.
И как в любой из научно-технических сфер, существует явление, которое предполагает использование технологии в военных или террористических целях. Таковой является чёрная биотехнология, включающая в себя биотерроризм, создание биологического оружия, воздействие на биологические объекты с противоправными целями.
Поговорить сегодня актуальнее всего о красной биотехнологии. И понятно почему: охватившая мир пандемия короновируса COVID-19 привлекла пристальное внимание к этой сфере. Все с нетерпением ждут создания вакцины против нового мирового бедствия, а также активно обсуждают тесты и лечебные препараты для борьбы с заболеванием.
Следует отметить, что настоящая эра биотехнологий в медицине началась с момента появления и начала массового внедрения вакцинации, вторым знаковым этапом стало создание первых антибиотиков. С тех пор развитие этой сферы продолжается неуклонно.
Ещё с советских времён на территории СССР развивалась собственная наукоёмкая отрасль, в которой «красная» ветка биотехнологий получала новые вакцины, лекарства, изучались штаммы бактерий и вирусов, угрожающих здоровью людей.
Были созданы уникальные научные центры, объединённые в НПО «Биопрепарат», созданное в 1973 году. Располагались они в России и Казахстане. Вакцины и лекарства, разработанные и произведенные этим НПО и другими НИИ и предприятиями страны, обеспечивали качественный уровень здравоохранения в СССР.
Были и примеры совместной, общей борьбы со страшными болезнями, поражавшими людей во всём мире. И как пример такого замечательного сотрудничества – история с вакцинацией против полиомиелита, когда советские учёные на базе разработок американских микробиологов создали препарат, о котором американский вирусолог А. Сейбин, создатель противополиомиелитной вакцины, в 1961 г. сказал: «Русские провели молниеносную войну против полиомиелита и победили, затратив на поражение противника в десять раз меньше времени, чем американцы».
После 1990-х годов биотехнологическая отрасль и России, и других стран постсоветского пространства пребывала в упадке достаточно долго. Но сегодня, осознав важность этой отрасли для государственной безопасности, в странах ЕАЭС развивают собственные исследовательские и производственные проекты в этой сфере.
Так, в Беларуси была принята «Концепция развития фармацевтической и биотехнологической промышленности Республики Беларусь на 2011-2015 годы и на период до 2020 года, а также «План развития биотехнологической отрасли Беларуси на 2012 – 2015 гг. и на период до 2020 года».
Россия в 2012 году также приняла «Комплексную программу развития биотехнологий в Российской Федерации до 2020 года», результатами реализации которой должны стать увеличение в 8,3 раза объема потребления биотехнологической продукции; увеличение объема её производства в стране в 33 раза; сокращение доли импорта на 50%; увеличение доли экспорта более чем в 25 раз.
Это самые разные разработки – от создания новейших антибиотиков до лекарств против «бичей двадцать первого века» – заболеваний сердечно-сосудистой системы, диабета, рака. Удивительными кажутся результаты российской разработки «искусственной кожи» Института теоретической и экспериментальной биофизики РАН, позволяющей значительно облегчить заживление тяжёлых ожогов и ран. Так что в плане уникальных биотехнологий российская наука не стоит на месте. Но вот извлекать финансовую прибыль из своих наработок российские учёные по-прежнему не слишком умеют.
Согласно статистике, объем мирового рынка биотехнологий в 2025 году планировался на уровне 2 трлн долларов и его рост по отдельным сегментам меняется от 5–7% до 30% в год. Рейтинг Financial Times Global 500 ещё в 2015 году поставил секторы биотехнологии и фармацевтики на 3-е место в мире. Доля России на этом рынке в 2019 году составляла менее 0,1%, а по ряду сегментов (биоразлагаемые материалы, биотопливо) близка к нулю. Однако попытки продолжать развитие собственной базы продолжаются, чему свидетельство – оперативно проведенные разработки собственных тестов на определение коронавирусной инфекции организма, а также лекарственных средств и вакцин.
В связи с охватившей мир пандемией коронавируса и возможным нарастанием биологической опасности, вызываемой мутирующими вирусами и бактериями, всё же есть шанс, что отрасль получит новые стимулы к развитию. Например, на фоне борьбы с вирусом менеджеры Сбербанка для поддержки создания вакцин и лекарств от коронавируса направят федеральному «Национальному исследовательскому центру эпидемиологии и микробиологии имени академика Н.Ф. Гамалеи», Государственному научному центру вирусологии и биотехнологии «Вектор» и другим исследовательским организациям выделенные банком и собранные средства. Общая сумма составит 3 млрд рублей.
К сожалению, биотехнологии, используемые и разрабатываемые, как уже упоминалось, могут быть не только «красными», «зелёными» и т. д., но и «чёрными». И развитие подобных «красно-чёрных» технологий с помощью тех же США в лабораториях, созданных этим государством в Казахстане, Армении, Украине и Грузии, явно принесёт много проблем в будущем.
Ещё в 2018 году, в ходе встречи глав внешнеполитических ведомств стран ОДКБ в Алматы, министр иностранных дел РФ Сергей Лавров заявил о «желании России получить доступ к референс-лабораториям, открытым при финансовой поддержке США на территории Армении и Казахстана. Наши спецслужбы и ученые напряжены появлением этих лабораторий, не исключая, что это как-то может быть впоследствии использовано против нас. Они же [США] их в Западной Европе не ставят…».
То есть на территориях этих государств ведут исследовательскую работу сотрудники иных стран, ведут в условиях секретности, что не может не вызывать вопросов у экономических и политических партнёров ОДКБ, в первую очередь у России. Подобные вопросы в условиях возникшей сегодня биологической опасности мирового масштаба, которую продемонстрировали события начала 2020 года, ведут к усилению повышенной напряжённости и недоверия.
А вот совместное развитие странами ЕАЭС мирного «красного» биотеха, способного как раз останавливать эпидемиологические угрозы, будь они рукотворны или природного происхождения, несомненно стоит поощрять, как и мероприятия в этой сфере. На осень 2020 года в Москве запланированы международный форум «Биотехнологии: состояние и перспективы развития» и выставка «Биотехпром и аналитика», конкурс молодых учёных, что может стать очередной точкой сборки всех лиц и организаций, заинтересованных в развитии этого важного направления науки и экономики.

Правила комментирования
comments powered by Disqus